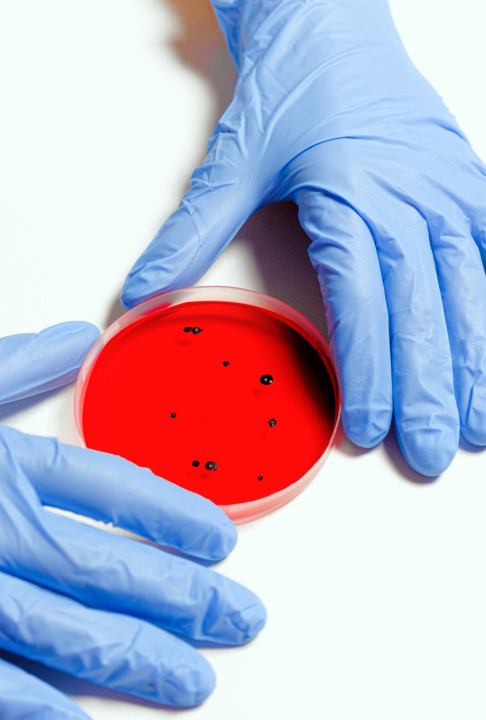

I onda kažu da ZDRAVLJE NEMA CENU - novi LEK protiv HEMOFILIJE košta čak - 3,5 MILIONA DOLARA
Ova bolest pogađa jednu osobu u 40.000, od kojih su većina muškarci
24.11.2022
SrbijaIstraživači navode da se šanse za zarazu sve veće, jer sve više ljudi dolazi na Arktik iz komercijalnih razloga
podeli vest:

Zombi virus amebe star 48.500 godina otkriven je u Sibiru i smatra se da on još poseduje zarazni potencijal.
Francuski istraživači otkrili su 13 virusa u permafrostu, za koje se veruje da se genomski razlikuju u odnosu na do sada poznate viruse. “Zombi virus” star 48.500 godina pronađen je ispod jezera, a ostali virusi u ostacima mamutske vune i u crevima sibirskog vuka. Tim naučnika tvrdi da ovi virusi i dalje imaju patogeni potencijal.
Foto: Pexels.com
Klimatske promene praćenje zagrevanjem planete, uslovile su otapanje velikih količina permafrosta i oslobađanje mikroba i virusa, koji milenijumima obitavaju u ledu. Kako bi proučili mikrobe u nastajanju, naučnici su oživeli veliki broj ovih „zombi virusa“ iz sibirskog permafrosta, uključujući i jedan za koji se smatra da je star skoro 50.000 godina, što je rekordna starost za zamrznuti virus koji je sposoban da se vrati u prvobitno stanje i počne da se razmnožava.
Tim naučnika predvođen mikrobiologom Jean-Marie Alempic iz francuskog Nacionalnog centra za naučna istraživanja (The French National Centre for Scientific Research), kaže da su ovi reanimirajući virusi potencijalno značajna pretnja javnom zdravlju. On navodi da su potrebna dalja istraživanja, kako bi se procenila moguća opasnost od infektivnih agenasa.
Ova bolest pogađa jednu osobu u 40.000, od kojih su većina muškarci
24.11.2022
SrbijaKada žena dođe u zrele godine, i kada sve naizgled počinje da se smiruje, javlja se menopauza, a sa njom i veoma neprijatni valunzi
23.11.2022
VestiJedna četvrtina severne hemisfere pokrivena je trajno smrznutim tlom, koji se naziva permafrost. Usled zagrevanja klime dolazi do odmrzavanja permafrosta koji počinje da oslobađa organske materije zamrznute milenijumima. Većina ovih materija se razlaže na ugljen-dioksid i metan, oslobađa u atmosferu i dodatno pojačava efekat staklene bašte, objašnjavaju stručnjaci.
- Primećeno je da se sa klimatskim promenama i zagrevanjem planete i veliki broj bakterija oslobađa u životnu sredinu, ipak protiv njih se možemo boriti antibioticima. Mnogo problematičniji za javno zdravlje mogu biti novi virusi, kao što je SARS-CoV-2. Situacija bi bila mnogo ozbiljnija, ukoliko bi se usled oživljavanja drevnog nepoznatog virusa, javile bolesti koje bi mogle da pogode ljude, životinje i biljke. Legitimno je razmišljati o rizicima i mogućnosti da se neki drevni virus odmrzne usled topljenja peramfrosta i vrati u cirkulaciju - pišu istraživači, u radu koji bi tek trebalo da bude objavljen.

Foto: Pexels.com
Prethodna studija detaljno je opisala otkriće virusa starog 30.000 godina. To je bio pandoravirus, gigant dovoljno velik da se vidi pomoću svetlosnog mikroskopa. Najnoviji virus, čija se starost procenjuje na oko 50.000 godina dobio je ime Pandoravirus yedoma, što potvrđuje njegovu veličinu i tip tla permafrosta u kojem je pronađen. Istraživači veruju da postoji mnoštvo drugih virusa koji ne ciljaju samo na amebe.
Stručnjaci ističu i da su nam nepoznati mnogi virusi, koji se oslobađaju zbog otapanja leda i dodaju da ostaje da se vidi u kojoj meri su ovi virusi zarazni, kada se izlože dejstvu svetlosti, toplote i kiseonika.
Pametni telefoni, tablet, televizor i računar sami po sebi nisu ni dobri ni loši. Sve zavisi od toga kako ih koristimo
25.11.2022
MozaikEpizode sezonske depresije javljaju se u istom periodu, počinju u jesen i traju do kraja zime
24.11.2022
VestiVirusolog Eric Delwart sa Kalifornijskog univerziteta u San Francisku (The University of California – San Francisco), koji nije bio uključen u studiju slaže se da su ovi džinovski virusi samo početak kada je u pitanju istraživanje onoga što se krije ispod permafrosta.
- Ukoliko autori izoluju žive viruse iz drevnog permafrosta, verovatno je da su preživeli čak i manji, jednostavniji virusi sisara zamrznuti eonima - rekao je Delwart.
Foto: Pexel.com

Istraživači navode da neki drevni virus “zombi virus” može biti potencijalno opasan za ljude. Napominje se de je 2016. godine jedno dete umrlo, a desetine osoba hospitalizovano, posle izbijanja antraksa u Sibiru. Zvaničnici veruju da je tadašnja epidemija počela, jer je toplotni talas odmrznuo permafrost i trup irvasa zaraženog antraksom. U epidemiji je uginulo oko 2.300 irvasa.
Nije do kraja jasno, da li bi neki drevni virus mogli da zarazi organizam domaćina u uslovima kada je izložen toploti, UV zracima, delovanju kiseonika. Istraživači koji učestvuju u ovoj studiji navode da se šanse za zarazu sve veće, jer se dobar deo permafrosta topi, a istovremeno sve više ljudi dolazi na Arktik iz komercijalnih razloga.
Doslovan prevod engleske reči permafrost je “trajni mraz”, a njom se u nauci definiše zamrznuto tlo koje se na temperaturi ispod nule, bez prekida, nalazi najmanje dve godine. Nekada ovo stanje može da traje i nekoliko hiljada godina.
Od raka grlića materice svakog dana u Srbiji umre jedna žena, a četiri obole
21.11.2022
VestiZbog dugog sedenje u neprirodnom položaju, gde su noge prekrštene, a pritom su mišići napeti, dolazi do pritiskanja krvnih sudova
21.11.2022
SrbijaTest krvi na dodir dugmeta, bez korišćenja igle, osmislili su istraživači sa University of California
21.11.2022
VestiStručnjaci su izneli svoj stav, pa vi odlučite sami
21.11.2022
Vesti
Ostavite komentar
Hm
Ali kada amerikanci krenu da nalaze svasta u Rusiji u jeku rata i medjusobnih sankcija i proterivanja.......... Treba nove v@kcine, jos nas niste sve pobili